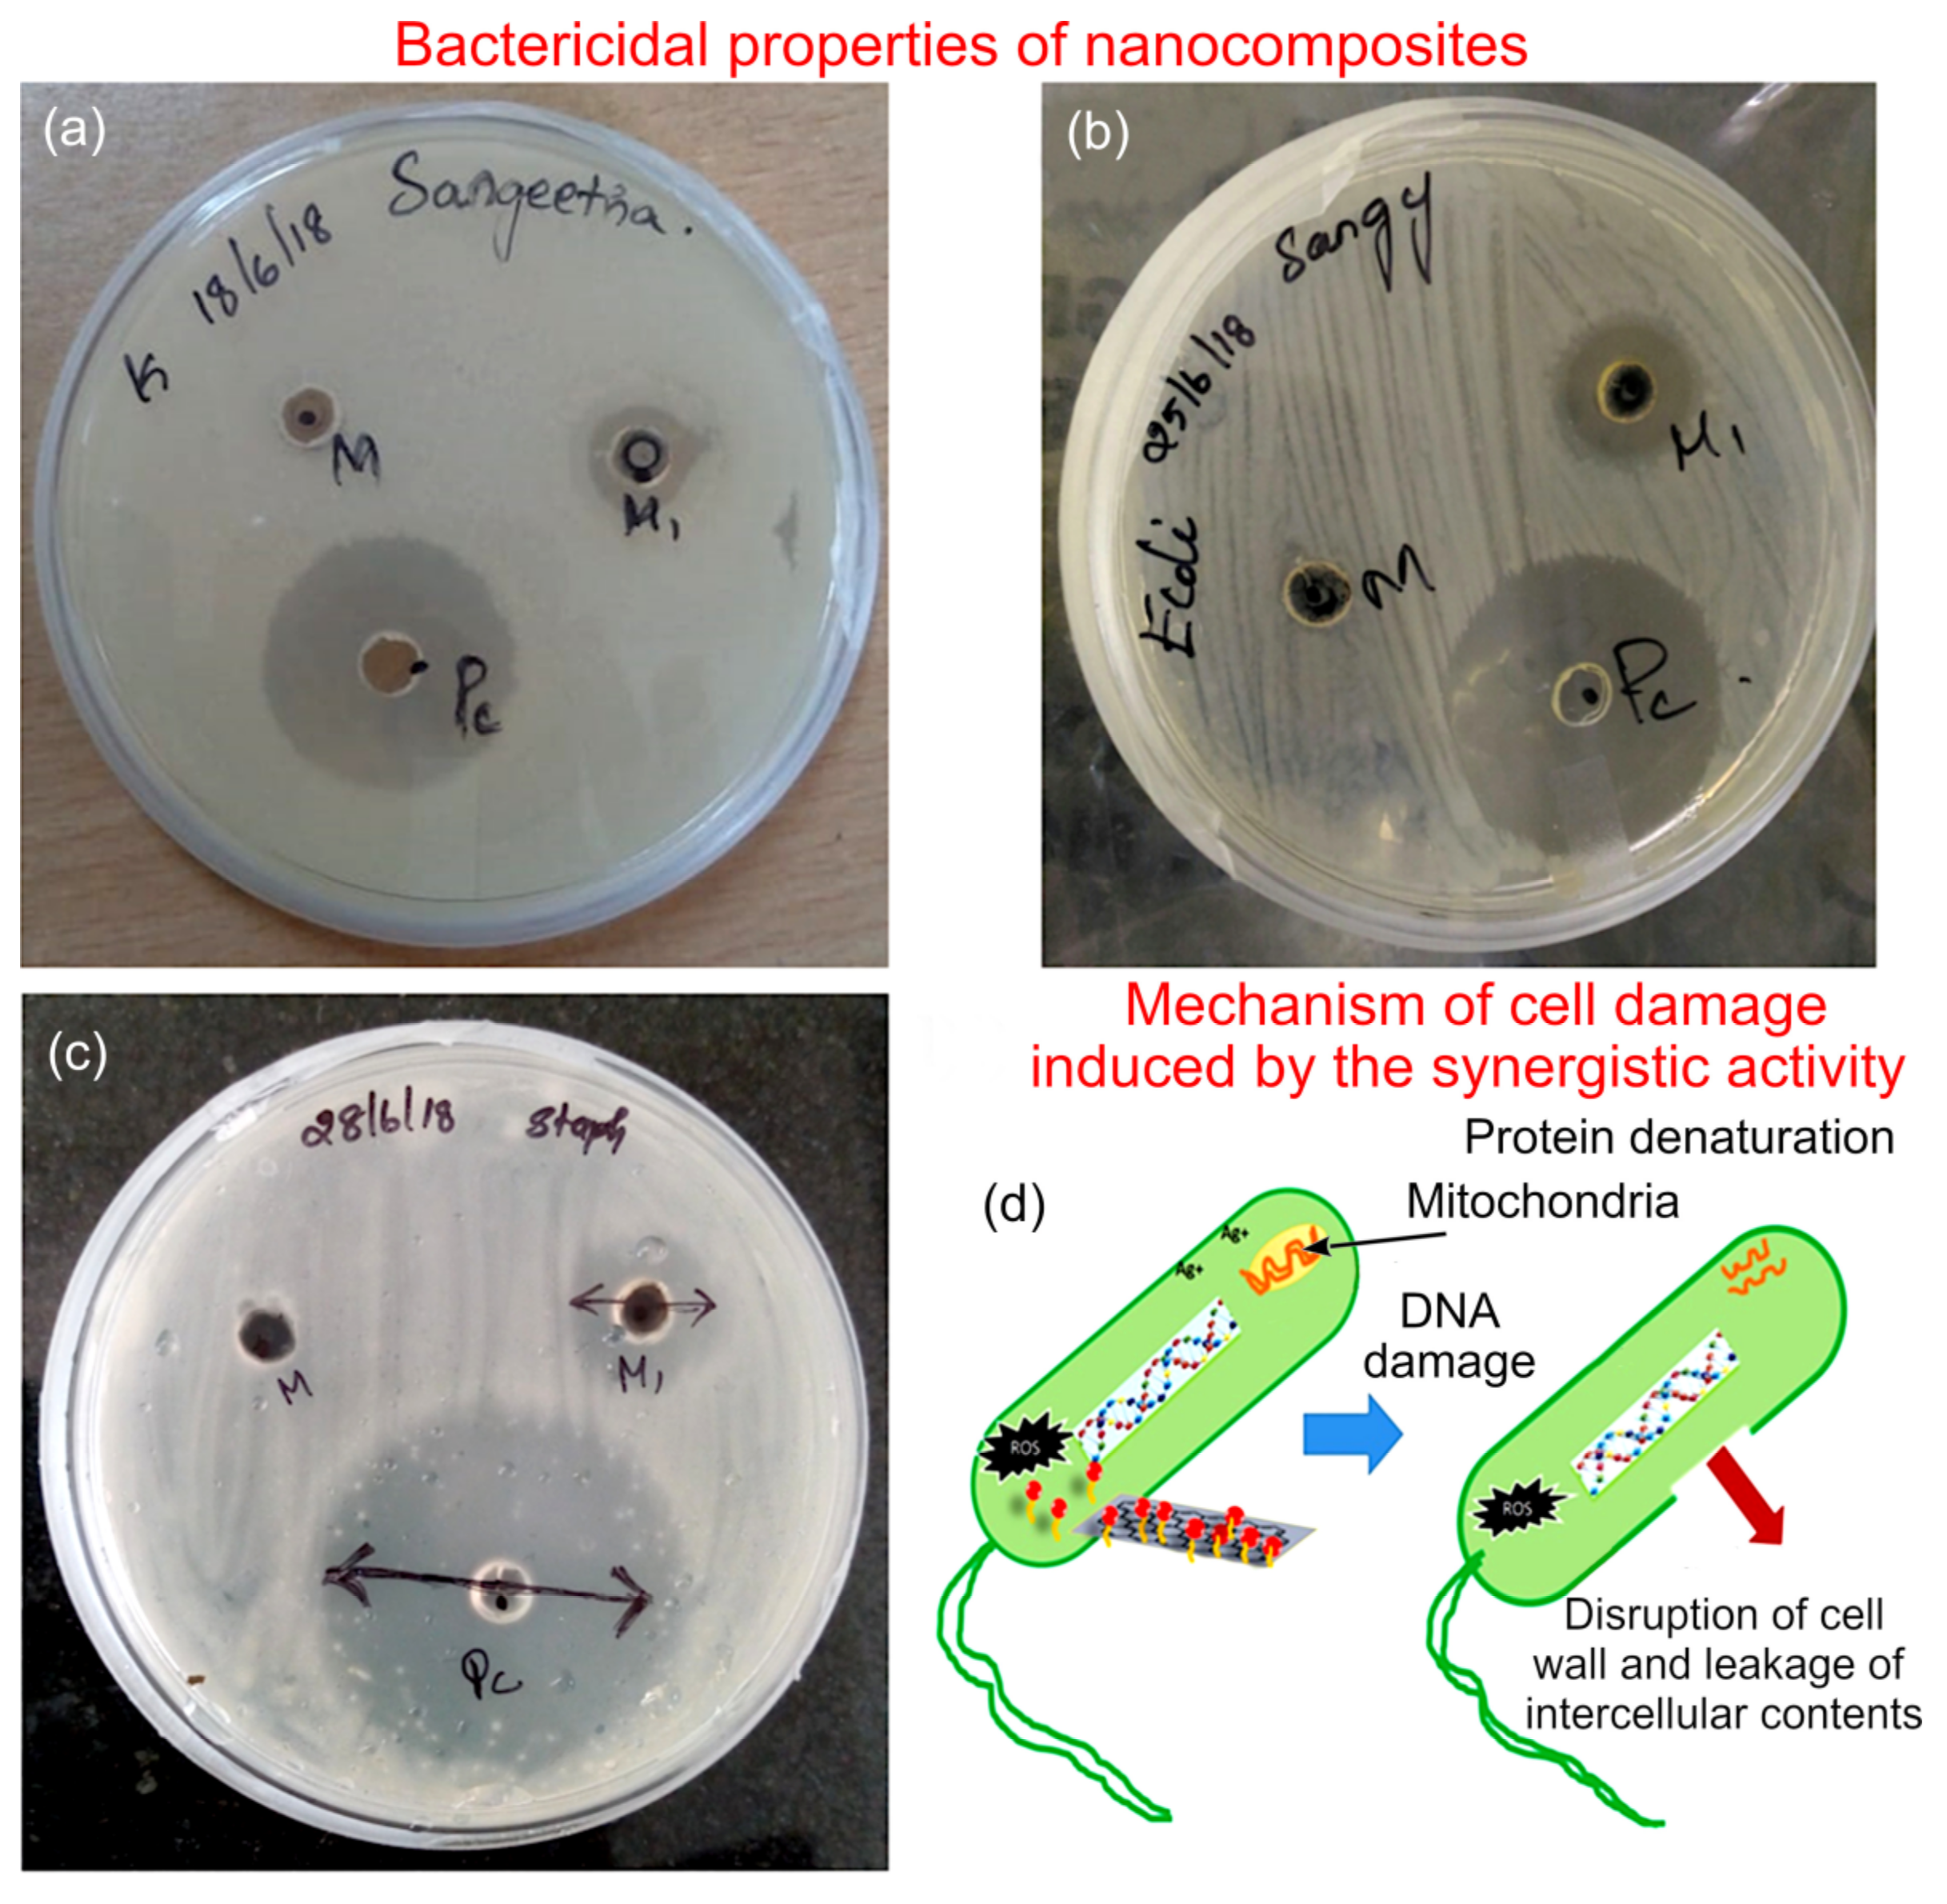
Molecules 27 05950 g007

Antioxidant, Anti-Bacterial, and Congo Red Dye Degradation Activity of AgxO-Decorated Mustard Oil-Derived rGO Nanocomposites
Abstract
:1. Introduction
2. Experimental
2.1. Material Synthesis
2.2. Material Characterization
3. Results and Discussion
4. Conclusions
Supplementary Materials
Author Contributions
Funding
Data Availability Statement
Conflicts of Interest
References
- DeMarini, D.M.; Carreón-Valencia, T.; Gwinn, W.M.; Hopf, N.B.; Sandy, M.S.; Bahadori, T.; Calaf, G.M.; Chen, G.; Conti, A.; Fritschi, L.; et al. Carcinogenicity of some aromatic amines and related compounds. Lancet 2020, 21, 1017–1018. [Google Scholar] [CrossRef]
- Wang, S.; Hanna, D.; Sugamori, K.S.; Granta, D.M. Primary aromatic amines and cancer: Novel mechanistic insights using 4-aminobiphenyl as a model carcinogen. Pharmacol. Therapeut. 2019, 200, 179–189. [Google Scholar] [CrossRef] [PubMed]
- Ngo, A.C.R.; Tischler, D. Microbial degradation of azo dyes: Approaches and prospects for a hazard-free conversion by microorganisms. Int. J. Environ. Res. Public Health 2022, 19, 4740. [Google Scholar] [CrossRef] [PubMed]
- Al-Tohamy, R.; Ali, S.S.; Li, F.; Okasha, K.M.; Mahmoud, Y.A.-G.; Elsamahy, T.; Jiao, H.; Fu, Y.; Sun, J. A critical review on the treatment of dye-containing wastewater: Ecotoxicological and health concerns of textile dyes and possible remediation approaches for environmental safety. Ecotoxicol. Environ. Saf. 2022, 231, 113160. [Google Scholar] [CrossRef]
- Sridharan, R.; Krishnaswamy, V.; Archana, K.M.; Rajagopal, R.; Kumar, D.T.; Doss, C.G.P. Integrated approach on azo dyes degradation using laccase enzyme and Cul nanoparticle. SN Appl. Sci. 2021, 3, 370. [Google Scholar] [CrossRef]
- Solís, M.; Solís, A.; Pérez, H.I.; Manjarrez, N.; Flores, M. Microbial decolouration of azo dyes: A review. Proc. Biochem. 2012, 47, 1723–1748. [Google Scholar] [CrossRef]
- Binupriya, A.R.; Sathishkumar, M.; Swaminathan, K.; Kuz, C.S.; Yun, S.E. Comparative studies on removal of Congo red by native and modified mycelial pellets of Trametes versicolor in various reactor modes. Bioresour. Technol. 2008, 99, 1080–1088. [Google Scholar] [CrossRef]
- González-Gutiérrez, L.V.; González-Alatorre, G.; Escamilla-Silva, E.M. Proposed pathways for the reduction of a reactive azo dye in an anaerobic fixed bed reactor. World J. Microbiol. Biotechnol. 2009, 25, 415–426. [Google Scholar] [CrossRef]
- Tamilselvi, R.; Ramesh, M.; Lekshmi, G.S.; Bazaka, O.; Levchenko, I.; Bazaka, K.; Mandhakini, M. Graphene oxide-based supercapacitors from agricultural wastes: A step to mass production of highly efficient electrodes for electrical transportation systems. Renew. Energ. 2020, 151, 731–739. [Google Scholar] [CrossRef]
- Tamilselvi, R.; Lekshmi, G.S.; Padmanathan, N.; Selvaraj, V.; Bazaka, O.; Levchenko, I.; Bazaka, K.; Mandhakini, M. NiFe2O4/rGO nanocomposites produced by soft bubble assembly for energy storage and environmental remediation. Renew. Energ. 2022, 181, 1386–1401. [Google Scholar] [CrossRef]
- Benzait, Z.; Chen, P.; Trabzon, L. Enhanced synthesis method of graphene oxide. Nanoscale Adv. 2021, 3, 223–230. [Google Scholar] [CrossRef]
- Hummers, W.S.; Offeman, R.E. Preparation of Graphitic Oxide. J. Am. Chem. Soc. 1958, 80, 1339. [Google Scholar] [CrossRef]
- Romero, A.; Lavin-Lopez, M.P.; Sanchez-Silva, L.; Valverde, J.L.; Paton-Carrero, A. Comparative study of different scalable routes to synthesize graphene oxide and reduced graphene oxide. Mater. Chem. Phys. 2018, 203, 284–292. [Google Scholar] [CrossRef]
- Levchenko, I.; Mandhakini, M.; Prasad, K.; Bazaka, O.; Ivanova, E.P.; Jacob, M.V.; Baranov, O.; Riccardi, C.; Roman, H.E.; Xu, S.; et al. Functional nanomaterials from waste and low-value natural products: A technological approach level. Adv. Mater. Technol. 2022, 7, 2101471. [Google Scholar] [CrossRef]
- Piferi, C.; Bazaka, K.; D’Aversa, D.L.; Di Girolamo, R.; De Rosa, C.; Roman, H.E.; Riccardi, C.; Levchenko, I. Hydrophilicity and hydrophobicity control of plasma-treated surfaces via fractal parameters. Adv. Mater. Interfaces 2021, 8, 2100724. [Google Scholar] [CrossRef]
- Piferi, C.; Carra, C.; Bazaka, K.; Roman, H.E.; Dell’Orto, E.C.; Morandi, V.; Levchenko, I.; Riccardi, C. Controlled deposition of nanostructured hierarchical TiO2 thin films by low pressure supersonic plasma jets. Nanomaterials 2022, 12, 533. [Google Scholar] [CrossRef]
- Hong, H.; Xiong, G.; Dong, Z.; Kear, B.H.; Tse, S.D. Open-atmosphere flame synthesis of monolayer graphene. Carbon 2021, 182, 307–315. [Google Scholar] [CrossRef]
- Zhang, C.; Tian, B.; Chong, C.T.; Ding, B.; Fan, L.; Chang, X.; Hochgreb, S. Open-atmosphere flame synthesis of monolayer graphene. Combust. Flame 2022, 238, 111939. [Google Scholar] [CrossRef]
- Kandasamy, A.; Ramasamy, T.; Samrin, A.; Narayanasamy, P.; Mohan, R.; Bazaka, O.; Levchenko, I.; Bazaka, K.; Mohandas, M. Hierarchical doped gelatin-derived carbon aerogels: Three levels of porosity for advanced supercapacitors. Nanomaterials 2020, 10, 1178. [Google Scholar] [CrossRef]
- Lekshmi, G.S.; Tamilselvi, R.; Geethalakshmi, R.; Kirupha, S.D.; Bazaka, O.; Levchenko, I.; Bazaka, K.; Mandhakini, M. Biowaste valorization by conversion to nanokeratin-urea composite fertilizers for sustainable and controllable nutrient release. Carbon Lett. 2021, 31, 763–777. [Google Scholar] [CrossRef]
- Carra, C.; Medvids, A.; Litvinas, D.; Ščajev, P.; Malinauskas, T.; Selskis, A.; Roman, H.E.; Bazaka, K.; Levchenko, I.; Riccardi, C. Hierarchical carbon nanocone-silica metamaterials: Implications for white light photoluminescence. ACS Appl. Nano Mater. 2022, 5, 4787–4800. [Google Scholar] [CrossRef]
- Banarjee, P.; Satapathy, M.; Mukhopahayay, A.; Das, P. Leaf extract mediated green synthesis of silver nanoparticles from widely available Indian plants: Synthesis, characterization, antimicrobial property and toxicity analysis. Bioresour. Bioprocess 2014, 1, 3. [Google Scholar] [CrossRef]
- Ahmad, S.A.; Das, S.S.; Khatoon, A.; Ansari, M.T.; Afzal, M.; Hasnain, M.S.; Nayak, A.K. Bactericidal activity of silver nanoparticles: A mechanistic review. Mater. Sci. Technol. 2020, 3, 756–769. [Google Scholar] [CrossRef]
- Marimuthu, S.; Antonisamy, A.J.; Malayandi, S.; Rajendran, S.; Tsai, P.-C.; Pugazhendhi, A.; Ponnusamy, V.K. Silver nanoparticles in dye effluent treatment: A review on synthesis, treatment methods, mechanisms, photocatalytic degradation, toxic effects and mitigation of toxicity. J. Photochem. Photobiol. B Biol. 2020, 205, 111823. [Google Scholar] [CrossRef]
- Hussain, I.; Singh, N.B.; Singh, A.; Singh, H.; Singh, S.C. Green synthesis of nanoparticles and its potential application. Biotechnol. Lett. 2016, 38, 545–560. [Google Scholar] [CrossRef]
- Kumari, R.M.; Thapa, N.; Gupta, N.; Kumar, A.; Nimesh, S. Antibacterial and photocatalytic degradation efficacy of silver nanoparticles biosynthesized using Cordia dichotoma leaf extract. Adv. Nat. Sci. Nanosci. Nanotechnol. 2016, 7, 045009. [Google Scholar] [CrossRef]
- Maiti, S.; Kundu, S.; Ghosh, D.; Mondal, S.; Roy, C.N.; Saha, A. Synthesis and spectral measurements of sulphonated graphene: Some anomalous observations. Phys. Chem. Chem. Phys. 2016, 18, 6701. [Google Scholar] [CrossRef]
- Kumar, A.; Aljumaili, A.; Bazaka, O.; Ivanova, E.P.; Levchenko, I.; Bazaka, K.; Jacob, M. Functional nanomaterials, synergism and biomimicry for environmentally benign marine antifouling technology. Mater. Horiz. 2021, 8, 3201–3238. [Google Scholar] [CrossRef]
- Yoo, J.-Y.; Jang, E.-Y.; Jeong, S.-Y.; Hwang, D.-Y.; Son, H.-J. Bacterial indoleacetic acid-induced synthesis of colloidal Ag2O nanocrystals and their biological activities. Bioprocess Biosyst. Eng. 2019, 42, 401–414. [Google Scholar] [CrossRef]
- Kumaran, A.; Karunakaran, R.J. Antioxidant and free radical scavenging activity of an aqueous extract of Coleus aromaticus. Food Chem. 2006, 97, 109–114. [Google Scholar] [CrossRef]
- Wadikar, D.D.; Patki, P.E. Coleus aromaticus: A therapeutic herb with multiple potentials. J. Food Sci. Technol. 2016, 53, 2895–2901. [Google Scholar] [CrossRef]
- Blois, M.S. Antioxidant determinations by the use of a stable free radical. Nature 1958, 29, 1199–1200. [Google Scholar] [CrossRef]
- Kim, J.; Raj, M.R.; Lee, G. High-defect-density graphite for superior-performance aluminum-ion batteries with ultra-fast charging and stable long life. Nano-Micro Lett. 2021, 13, 171. [Google Scholar] [CrossRef]
- Sherin, J.; Kumar, P.S.; Karuthapandian, S. Leaf extract arbitrated biogenic synthesis of silver nanospheres by a medicinal plant from the western ghats with enhanced antimicrobial property. Photochem 2021, 1, 264–274. [Google Scholar] [CrossRef]
- Khan, M.Z.M.; Tareq, F.K.; Hossen, M.A.; Roki, M.N.A. Green synthesis and characterization of silver nanoparticles using Coriandrum sativum leaf extract. J. Eng. Sci. Technol. 2018, 13, 158–166. [Google Scholar]
- Haq, S.; Rehman, W.; Waseem, M.; Meynen, V.; Awan, S.U.; Saeed, S.; Iqbal, N.J. Fabrication of pure and moxifloxacin functionalized silver oxide nanoparticles for photocatalytic and antimicrobial activity. Photochem. Photobiol. B Biol. 2018, 186, 116–124. [Google Scholar] [CrossRef]
- Krishnamoorthy, M.; Veerapandian, R.; Mohan, R.; Kim, S. Investigation of Raman and photoluminescence studies of reduced graphene oxide sheets. Appl. Phys. A Mater. Sci. Process 2012, 106, 501. [Google Scholar] [CrossRef]
- Perumbilavil, S.; Sankar, P.; Thankamani, P.R.; Philip, R. White light Z-scan measurements of ultrafast optical nonlinearity in reduced graphene oxide nanosheets in the 400–700 nm region. Appl. Phys. Lett. 2015, 107, 051104. [Google Scholar] [CrossRef]
- Lee, S.H.; Jun, B.-H. Silver nanoparticles: Synthesis and application for nanomedicine. Int. J. Mol. Sci. 2019, 20, 865. [Google Scholar] [CrossRef]
- Akhavan, O.; Ghaderi, E. Toxicity of graphene and graphene oxide nanowalls against bacteria. ACS Nano 2010, 4, 5731–5736. [Google Scholar] [CrossRef]
- Zhang, X.P.; Chen, Y.; Su, Y.; Wei, G.Z. Recent advances in the fabrication and structure-specific applications of graphene-based inorganic hybrid membranes. Nanoscale 2015, 7, 5080–5093. [Google Scholar]
- Liu, S.; Zeng, T.H.; Hofmann, M.; Burcombe, E.; Wei, J.; Jiang, R.; Kong, J.; Chen, Y. Antibacterial activity of graphite, graphite oxide, graphene oxide, and reduced graphene oxide: Membrane and oxidative stress. ACS Nano 2011, 5, 6971–6980. [Google Scholar] [CrossRef]
- Huo, J.; Zeng, H. Silver nanoparticles-sensitized cobalt complex for highly-efficient photocatalytic activity. Appl. Catal. B-Environ. 2016, 199, 342–349. [Google Scholar] [CrossRef]
- Zhu, W.; Gao, H.; Zheng, F.; Huang, T.; Wu, F.; Wang, H. Electrodeposition of graphene by cyclic voltammetry on nickel electrodes for microbial fuel cells applications. Int. J. Energy Res. 2019, 43, 2795–2805. [Google Scholar] [CrossRef]
- Wang, H.; Zhang, Q.; Li, J.-J.; Zhang, J.-Y.; Liu, Y.; Zhou, M.; Zhang, N.; Fang, Y.-Z.; Ke, Q. The covalent coordination-driven Bi2S3@NH2-MIL-125(Ti)-SH heterojunction with boosting photocatalytic CO2 reduction and dye degradation performance. J. Colloid Interface Sci. 2022, 606, 1745–1757. [Google Scholar] [CrossRef]
- Padmanabhan, N.T.; Thomas, N.; Louis, J.; Mathew, D.T.; Ganguly, P.; John, H.; Pillai, S.C. Graphene coupled TiO2 photocatalysts for environmental applications: A review. Chemosphere 2021, 271, 129506. [Google Scholar] [CrossRef]
- Ghasemipour, P.; Fattahi, M.; Rasekh, B.; Yazdian, F. Developing the ternary ZnO doped MoS2 nanostructures grafted on CNT and reduced graphene oxide (RGO) for photocatalytic degradation of aniline. Sci. Rep. 2020, 10, 4414. [Google Scholar] [CrossRef]
- Merrad, S.; Abbas, M.; Brahimi, R.; Trari, M. Study of Congo Red removal from aqueous solution by using the deficient perovskite SrTiO3-δ under solar light. J. Mol. Struct. 2022, 1265, 133349. [Google Scholar] [CrossRef]
- Dutta, S.; Gupta, B.; Srivastava, S.K.; Gupta, A.K. Recent advances on the removal of dyes from wastewater using various adsorbents: A critical review. Mater. Adv. 2021, 2, 4497–4531. [Google Scholar] [CrossRef]
- Bhattacharyya, A.; Chattopadhyay, R.; Mitra, S.; Crowe, S.E. Oxidative stress: An essential factor in the pathogenesis of gastrointestinal mucosal diseases. Physiol. Rev. 2014, 94, 329–354. [Google Scholar] [CrossRef] [PubMed]
- Jung, W.K.; Koo, H.C.; Kim, K.W.; Shin, S.; Kim, S.H.; Park, Y.H. Antibacterial activity and mechanism of action of the silver ion in Staphylococcus aureus and Escherichia coli. Appl. Environ. Microbiol. 2008, 74, 2171–2178. [Google Scholar] [CrossRef] [PubMed]
- Tu, Y.; Lv, M.; Xiu, P.; Huynh, T.; Zhang, M.; Castelli, M.; Liu, Z.; Huang, Q.; Fan, C.; Fang, H.; et al. Destructive extraction of phospholipids from Escherichia coli membranes by graphene nanosheets. Nat. Nanotechnol. 2013, 8, 594–601. [Google Scholar] [CrossRef] [PubMed]
- Workentine, M.L.; Harrison, J.J.; Stenroos, P.U.; Ceri, H.; Turner, R.J. Pseudomonas fluorescens’ view of the periodic table. Environ. Microbiol. 2007, 10, 238–250. [Google Scholar] [CrossRef]
- Lekshmi, G.S.; Tamilselvi, R.; Geethalakshmi, R.; Kirupha, S.D.; Bazaka, O.; Levchenko, I.; Bazaka, K.; Mandhakini, M. Multifunctional oil-produced reduced graphene oxide–Silver oxide composites with photocatalytic, antioxidant, and antibacterial activities. J. Colloid Interface Sci. 2022, 608, 294–305. [Google Scholar] [CrossRef]
- Kumar, S.R.; Ashish, J.; Satish, N. Momordica charantia Linn: A mini review. Int. J. Biomed. Res. 2011, 11, 579–587. [Google Scholar]
- Qiu, Y.; Wang, Z.; Owens, A.C.E.; Kulaots, I.; Chen, Y.; Kane, A.B.; Hurt, R.H. Antioxidant chemistry of graphene-based materials and its role in oxidation protection technolog. Nanoscale 2014, 6, 11744–11755. [Google Scholar] [CrossRef] [Green Version]

| Sample Type | Efficiency (%) | Rate Constant (k−1) |
|---|---|---|
| M−rGO | 67.77 | 0.750 |
| AgxO | 75.55 | 0.841 |
| M−rGO−AgxO | 81.89 | 0.951 |
| Zone of Inhibition ± SD, mm | |||
|---|---|---|---|
| Active Agent | K. pneumonia | E. coli | S. aureus |
| Chloramphenicol | 28 ± 2 | 28 ± 3 | 35 ± 4 |
| M−rGO | NIL | NIL | NIL |
| M−rGO−AgxO | 15 ± 2 | 18 ± 3 | 14 ± 2 |
Publisher’s Note: MDPI stays neutral with regard to jurisdictional claims in published maps and institutional affiliations. |
© 2022 by the authors. Licensee MDPI, Basel, Switzerland. This article is an open access article distributed under the terms and conditions of the Creative Commons Attribution (CC BY) license (https://creativecommons.org/licenses/by/4.0/).
Share and Cite
Lekshmi, G.S.; Ramasamy, T.; Bazaka, O.; Levchenko, I.; Bazaka, K.; Govindan, R.; Mandhakini, M. Antioxidant, Anti-Bacterial, and Congo Red Dye Degradation Activity of AgxO-Decorated Mustard Oil-Derived rGO Nanocomposites. Molecules 2022, 27, 5950. https://doi.org/10.3390/molecules27185950
Lekshmi GS, Ramasamy T, Bazaka O, Levchenko I, Bazaka K, Govindan R, Mandhakini M. Antioxidant, Anti-Bacterial, and Congo Red Dye Degradation Activity of AgxO-Decorated Mustard Oil-Derived rGO Nanocomposites. Molecules. 2022; 27(18):5950. https://doi.org/10.3390/molecules27185950
Chicago/Turabian StyleLekshmi, G. S., Tamilselvi Ramasamy, Olha Bazaka, Igor Levchenko, Kateryna Bazaka, Raji Govindan, and Mohandas Mandhakini. 2022. "Antioxidant, Anti-Bacterial, and Congo Red Dye Degradation Activity of AgxO-Decorated Mustard Oil-Derived rGO Nanocomposites" Molecules 27, no. 18: 5950. https://doi.org/10.3390/molecules27185950
APA StyleLekshmi, G. S., Ramasamy, T., Bazaka, O., Levchenko, I., Bazaka, K., Govindan, R., & Mandhakini, M. (2022). Antioxidant, Anti-Bacterial, and Congo Red Dye Degradation Activity of AgxO-Decorated Mustard Oil-Derived rGO Nanocomposites. Molecules, 27(18), 5950. https://doi.org/10.3390/molecules27185950

